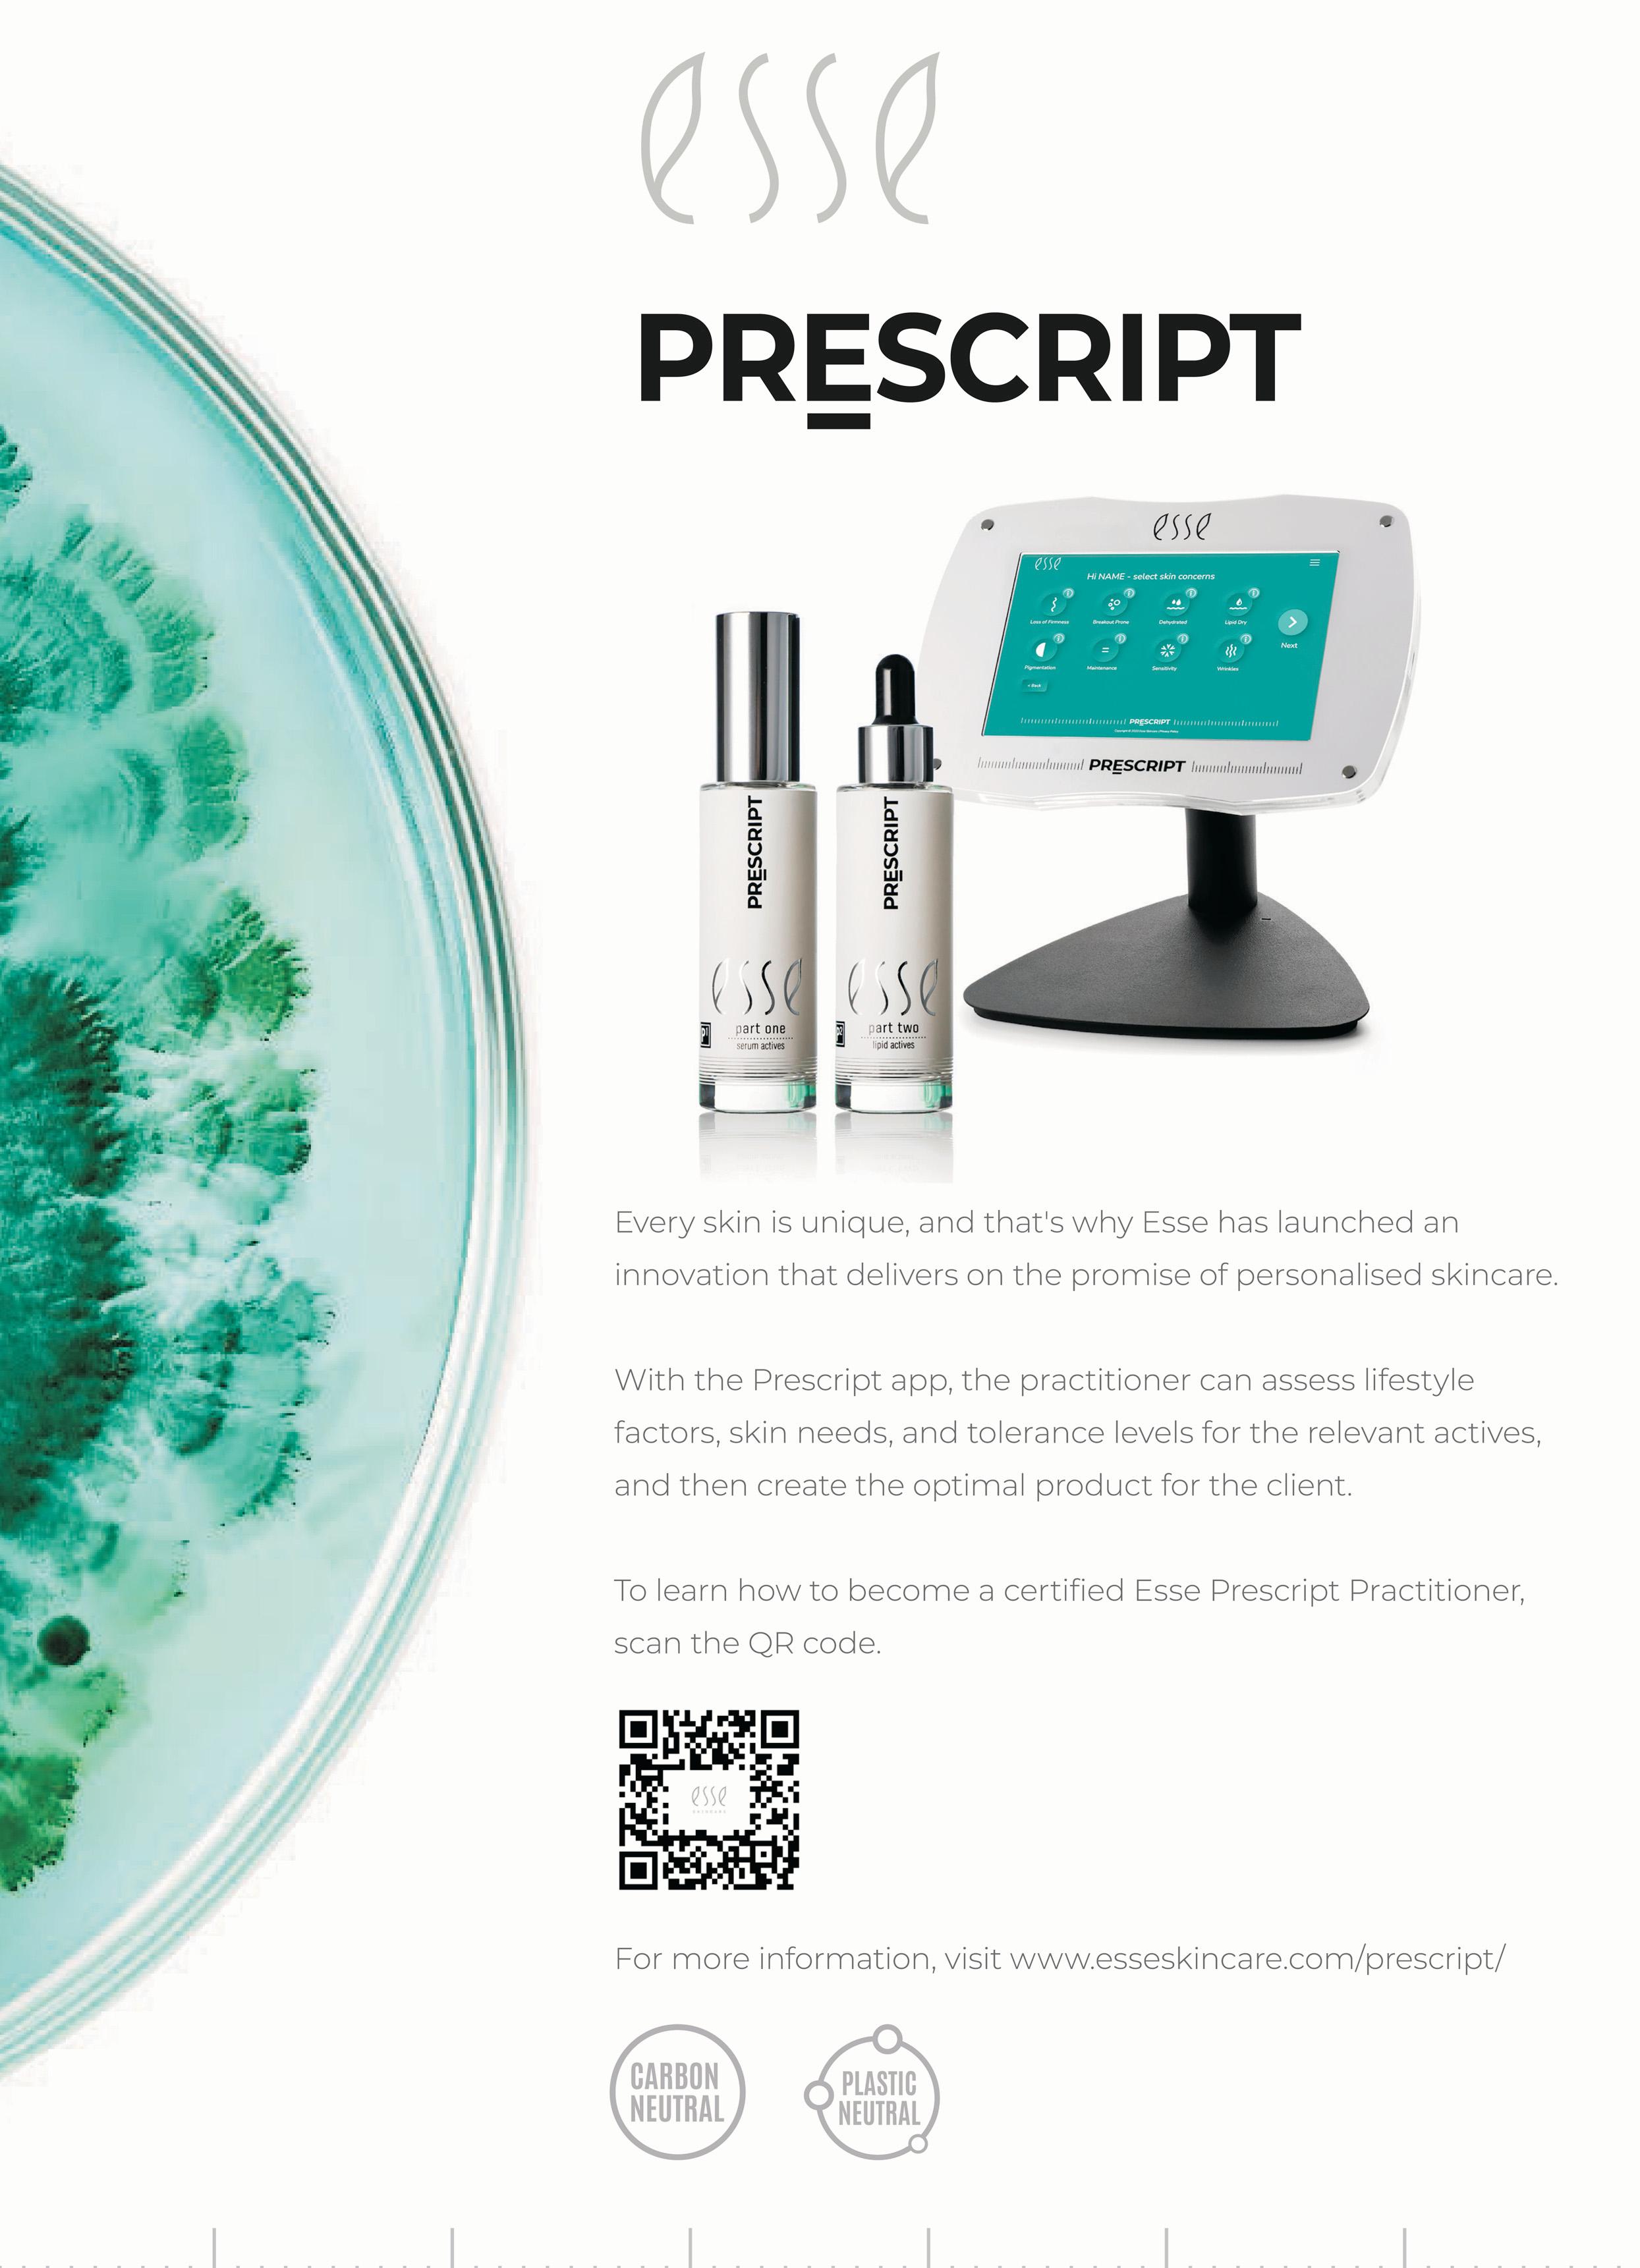

![]()



Doc: Coiffure : Jose Garcia
















Welcome to Les Nouvelles Esthetiques Spa Conference 2024, with the theme: Future Wellness Thinking.
The future of spas embraces an intricate blend of wellness, spa therapies, and innovative business practices. Envision personalized wellness journeys, sustainable initiatives, holistic treatments, and technology-integrated therapies. Spas are evolving into wellness hubs, where curated experiences transcend mere relaxation. Forward-thinking strategies are set to redefine industry benchmarks, forging a harmonious synergy of mind and body, while elevating the spa landscape. This evolution, positions spas not only as places of rejuvenation, but also as centers for comprehensive wellness, catering to the needs of a diverse range of clients. As the industry evolves, embracing these advancements will be crucial for spa businesses aiming to stay ahead in an increasingly competitive market.
Lastly, I would like to congratulate all the finalists and winners in the Les Nouvelles Eshtetiques Spa Awards 2024. The Spa Awards programme is more than pure recognition of achievement, it sets a benchmark for spas in Southern Africa, and all the finalists and winners are worthy of this acknowledgment.
Singapore • South Africa • Spain • Taiwan • Turkey • Ukraine • USA • Yugoslavia








Future Wellness Thinking. The future of spas embrace a intertwining of wellness, spa therapies, and business innovation. Anticipate personalized wellness journeys, sustainable practices, holistic therapies and tech-integrated therapies. Spa businesses will evolve into comprehensive wellness hubs, offering curated experiences that go beyond relaxation. Forward-thinking strategies will redefine industry standards, creating a harmonious synergy between mind, body, and business for an enriched spa landscape. Embrace the transformative wave of future spa thinking.
Les Nouvelles Esthetiques Spa Conference 2024 Southern Sun, Rosebank, Johannesburg 28 & 29 July 2024
Tel: 083 267 2773
E-mail: info@lesnouvelles.co.za Website: www.lesnouvelles.co.za











Sunday, 28th July 2024
MC: Mimmie Lancaster (Founder and Managing DirectorSymmetry World)
8.30 – 9.30 Registration
9.30 – 9.40 Welcome – Dr Nadine de Freitas (Managing Editor – Les Nouvelles Esthetiques & Spa)
9.45 - 10.30 Wellness Transformation - Debbie Merdjan (CEO Camelot Spa Group)
10.30 - 11.00 The Diverse World of Wellness Travel - Ingrid Wood (Publisher: YourLuxury Africa)
11.00 - 11.30 Mid Morning Break
11.30 - 12.15 Designing the New Spa Space - Jacoline Wentzel (Founder & Managing Director - The Spa Warehouse)
12.15 - 13.00 Elevate your Edge - Marisa Dimitridias (Founder and Managing Director - The Spa Consultants)
13.00 - 14.00 Lunch
14.00 - 14.30 Expanding Horizons: Integrative TherapiesMandy Trollip (Founder of The Soul Khaya)
14.30 - 15.30 Panel Discussion: Exploring the ever-evolving Landscape of Wellness Therapies. Chairperson: Ayesha Rajah - Founder Urban Bliss Wellness Spa and CEO Beauty Warriors). Panel: Mandy Trollip (The Soul Khaya), Toni Carroll (FounderMy Beauty Luv), Fatima Aboo Vally Mohamed (Holistic Healthcare Practitioner), Dr. Farhana Nakhooda (Homeopathic Doctor)
15.30 - 16.00 The Multifaceted Realm of Spa Talent - Miranda Forrester (MF Spa & Beauty Placements)
Les Nouvelles Esthétiques, now published in 26 countries, with head office in Paris, France, has been an international leader in providing upto-date wellness and spa information for the past 71 years through their international network of magazines, conference and exhibitions. The South African magazine edition of Les Nouvelles Esthetiques Spa Magazine launched in October 2002 and the Spa Conference and Spa Award in 2005 and has grown from strength to strength, as we focus on providing the industry with important information on new trends and up to date knowledge in the world of spas, encompassing all aspects of skincare, bodycare and spa therapies, spa design, spa management and spa lifestyle.
Enjoy the Read: https://issuu.com/lesnouvellessouthafrica
www.lesnouvelles.co.za
info@lesnouvelles.co.za / whats app: +27 83 267 2773
Monday, 29th July 2024
8.30 - 9.00 Registration
9.00 - 9.10 Welcome - Dr Nadine de Freitas (Managing Editor - Les Nouvelles Esthetiques & Spa
9.10 - 9.30 Personal PIN Code – Cracking the Code to Your Best Self - Rinus Le Roux
9.15 - 9.50 Unlock Exceptional Guest Experiences - Lisa Samuels (BABOR Product Expert)
9.50 - 10.30 Engagement Matters: Crafting Narrative Communication Strategies for Spa Successes across Generations - Nthabiseng Shongwe (Narrative Strategist & Director of Marketing Communication: Spiral Aloe Health & Wellness) and Dr Mothomang Diaho (Founder and Medical Director: Spiral Aloe Health & Wellness)
10.30 - 11.00 Personalization: Balancing Optimal EfficacyAlicia Stander (Education Specialist for Esse Skincare)
11.00 - 11.30 Mid Morning Tea Break
11.30 - 12.00 Unveiling Biohacking: Elevating Wellness through Science and Innovation - Dr Juanita Kilian (Founder and CEO, DrK Dermal Health)
12.00 - 12.20 Sante Wellness Retreat and Bio-energy Centre: Integrating Technology and Tranquility - Charlotte Strydom (Health Optimizing Clinic Manager)
12.20 - 13.00 Panel Discussion. "Wellness Technologies”: Charlotte Strydom (Health Optimizing Clinic Manager), Alicia Stander (Esse Skincare), Payal Singh (Geneticist at Skin Rejuvenation Technologies), Dr Juanita Kilian (DrK Dermal Health), Steve Uria (Wellness Director at Newmark Hotels & Reserves)
13.00 - 14.00Lunch
14.00 - 14.45 Crafting Your Future Spa Business Direction: Building Brand Equity - Tzvia Herman (Founder and CEO, The Laser Beautique Group)
14.45 - 15.30 From Passion to Purpose: Harnessing Client Insights for Spa Growth - Tebogo Thoka (Founder and CEO, FabuHealth & Co, The Skin Whisperer)
15.30 - 16.00 Embracing Gratitude and Human Connection - Esna Colyn (Chairperson of i-BLOOM Beauty)
16.00 Closing & Thank you – Dr Nadine de Freitas (Managing Editor – Les Nouvelles Esthetiques & Spa)
Dr Nadine de Freitas - Managing Editor – Les Nouvelles Esthetiques & Spa, African Edition
With a Masters Degree in Homeopathy (S.A) (Cum Laude), Dr Nadine de Freitas, Owner and Managing Editor of Spa Magazine Les Nouvelles Esthétiques - South Africa brings a wealth of knowledge to the spa industry, and is able to integrate the Spa Industry into a language that reaches professionals and spa visitors at all levels.
With a 25 years experience in holistic medicine, publishing and marketing, and a commitment to the growth and development of the Spa Industry, Nadine is additionally the Founder and Executive Director of the South African Spa Association, which acts as am ambassador for the industry, monitoring standards, building Industry confidence, identifying Industry needs, such as education, and collaborating with other industry bodies, so promoting South Africa as a spa destination of choice.
Debbie Merdjan - CEO Camelot Spa Group
Debbie Merdjan, CEO and founder of the Camelot Group, has over 30 years of experience with Health and Skincare Training Centres, Wellness Product Distribution, Spa consultancy, and 37 Spa Franchises across Africa. Awarded EY Entrepreneur Of The Year™ 2018, Best Spa Brand at the 2019 and 2021 Haute Grandeur Global Spa Awards™, and more, Debbie is passionate about business, entrepreneurship, and consulting. Based in the UK, she operates an International Spa and Product Distribution division with Thalgo UK. Debbie is also active in the WPO and the Global Wellness Institute.
Ingrid Wood - Publisher: YourLuxury Africa
“I have worked in the media and publishing industry for over 25 years across areas from writing, editing and content strategy, to project management and custom publishing.
My early days include immersion in the health and fitness space on Longevity magazine, before I moved to Elle South Africa as Beauty Editor. Over the years I have been fortunate to travel to many places around the globe thanks to my roles in the media industry, more recently as Publishing Director at Ndalo Media, overseeing brands Elle, Elle Decoration, Destiny, Destiny Man and as Editor of Sawubona, SAA’s inflight magazine.
I am currently Publisher and Special Projects Editor at YourLuxury Africa, a multi-platform media house that takes readers and followers on a journey through the world of luxury in a unique way. I still am and always will be a beauty and wellness addict at heart.”
Jacoline Wentzel is without a doubt passionate about the Spa Industry and is a respected industry representative and entrepreneur. Since 2005, Jacoline has been Managing director and leading spa consultant of The Spa Warehouse, a leading supplier of various prestigious spa brands, equipment and spa furniture as well as a consulting company that offers a variety of consulting and design services to 5 star spa establishments.
Since the start of The Spa Warehouse in 2005, Jacoline has established herself as one of the leading spa consultants in Africa and have consulted on more than 100 projects throughout Africa and Mauritius. Jacoline has also served on numerous boards in our industry throughout her career and has been a pioneer in establishing and improving the spa industry in South Africa.
Marisa Dimitriadis - Founder and Managing Director of The Spa Consultants
Her industry experience catalyzed tha her to launch her first solely owned venture, The Spa Consultants, answering a need in the market for a turnkey
consultancy to drive spa projects from the ground up. Today, they have successfully managed over 60 contracts in this space.
The next venture to be added to the portfolio was naturally brand development. Marisa formulated her own skin (SIX Skincare) and body (Spalicious) ranges, using only the best ingredients, recyclable packaging, offering value for money and very importantly, product education. Testament to her endeavouring spirit, the brands continue to grow with the addition of powerful aesthetic components to ensure her retail partners continue to offer cutting edge technology under the SIX Skincare umbrella.
The onset of a global pandemic did not deter Marisa. This drove her to launch an online retail platform (Send me That) for spa’s and salons. This brings us 360 to Marisa’s latest project. Spa Professionals Guild is a GLOBAL online platform for ongoing business coaching and transformational management courses. The platform offers networking, bi-monthly group coaching sessions, templates, spreadsheets and systems of best practices that have been perfected over the last 20 years to help business owners run profitable and sustainable businesses and offer offer therapists an opportunity for growth, increased income and to be considered for promotion. Since launching in July 2020, it has attracted members from 19 different countries and growing weekly.
Marisa has been nominated for, and won, numerous industry Awards such as: Spa Ambassador, Entrepreneur Awards, Woman in Business and many more.
Mandy
Trollip - Founder of The Soul Khaya
As both a businesswoman and a master holistic practitioner, Mandy has been deeply immersed in the world of conscious wellness for more than 3 decades. Whether engaged in her position as GM of JASMAR, contract manufacturers and curators of personal care products, or immersed in her private holistic therapy practice, The Soul Khaya, Mandy’s commitment is to infuse every aspect of your interactions with her in professionalism and authenticity. She is deeply rooted in the belief that living synergistically and intentionally within the ancient wisdoms of harmony, rhythm, and flow determines the quality of each day, and ultimately life.
Ayesha Rajah - Managing Director of A&I Importers, Somatologist
Ayesha Rajah has been a somatologist in the spa and skincare industry for over 20 years. She owns Urban Bliss Wellness Spa in Emmarentia and previously managed Aspira Aesthetic Spa in Hyde Park Shopping Centre for 15 years.
As Managing Director of A&I Importers, she has facilitated training for skincare brands Phytomer, PRIORI, and Skin Doctors. Ayesha holds a national diploma in Somatology from the University of Johannesburg, complemented by additional courses to stay updated with the latest technology.
She also runs @socialmedi8, a Social Media Marketing and Management company focused on the beauty industry, and has launched Beauty Warriors, a consumer-based website for professional beauty reviews.
Ayesha is passionate about imparting knowledge and empowerment, having presented at international and local conferences. She has also served as a mentor in the Global Mentorship Programme for the professional skincare industry.
Dr. Farhana Nakhooda - Homeopathic Doctor
Dr. Farhana Nakhooda, a qualified Homeopath with a master’s degree from the University of Johannesburg, offers a holistic approach to health. She is trained in Cupping Therapy and various complementary medicine techniques.
Her practice, Natural Wellness, integrates Homeopathy and Functional Medicine, addressing physical, mental, and emotional health. Dr. Farhana is dedicated to helping individuals from all backgrounds, managing chronic conditions and acute ailments.
Toni Carroll - Founder - My Beauty Luv
With over 22 years experience in the beauty, health and fitness industries, Toni Carroll is a pioneer in the ingestible beauty industry consulting for companies and owning her own luxury nutricosmetic brand MY BEAUTY LUV. Her passion is working with natural ingredients and she is one of SA’s top experts in the field of medicinal mushrooms. Toni has written articles for various magazines, been featured on radio and TV and her brand My Beauty Luv has won international awards for industry excellence.
Fatima Aboo Vally Mohamed
Formal Training: A 3-year Diploma in Culinary Arts/Chef and Hotel Management. Life led me to the Healing Arts, starting my Body Talk journey as a client in 2010. Intrigued by the non-invasive methodology, I pursued a career in this field from 2011.
Over the years, I became an Usui Reiki Master, Access Consciousness Bars Practitioner, and Energetic Facelift Practitioner. I also use the LifePrint Operating System to help clients understand and improve their relationships and behaviours.
As a Holistic Healthcare Practitioner, I offer:
- Facial Analysis & Tissue Salt Consultation
- Fascial Balancing & Intuitive Fascial Release
- Lymphatic Drainage
- Orthopedic Evaluation
My passion is helping individuals reach their potential in health, careers, relationships, and life in general.
Miranda Forrester - MF Spa & Beauty Placements
Qualified Health & Skin Care Therapist with nearly 2 decades of experience local and international.
Offers niche recruitment services and consultancy to Spa, Beauty and Hospitality professionals. Other turn-key services include Procurement, Training and Development and mentoring.
Executive recruiter and founder of MF Spa & Beauty Placements since 2017 – having secured over 500 jobs for industry professionals locally in SA and abroad in countries including Middle East, UK, New Zealand and Sri Lanka.
Miranda offers her candidates and clients a personal touch and take pride in building and maintaining relationships. Industry advisor for several academic institutions in SA promoting ethics and sustainability in the Spa & Beauty industry.
Le Roux
Are you ready to upgrade? Rinus Le Roux, a behavioral specialist, will speak about his book, “Personal PIN Code,” guiding you to unlock your potential and become the best version of yourself.
Rinus specializes in helping companies, teams, and individuals achieve their personal and professional goals. He captivates audiences with his insights into motivation, inspiration, and the drive to make a difference. His work has been praised for offering professionals gripping insights into finding meaning beyond success.
Lisa Samuels - BABOR Product Expert
Lisa Samuels is a distinguished professional in beauty and medical aesthetics with over 8 years of experience. Holding an Advanced Diploma in Dermal Aesthetics, she is a sought-after lecturer and thought leader. As a BABOR
Product Expert, Lisa ensures professionals and clients benefit from the latest skincare advancements. Her dedication to excellence and innovation has made her a Key Opinion Leader (KOL) in the industry. We are honored to have Lisa represent BABOR, driving the brand’s mission of delivering exceptional skincare solutions and education.
Nthabiseng Shongwe - Narrative Strategist | Writer & Poet | Director of Marketing Communication: Spiral Aloe Health & Wellness
With 10 years of experience in the Marketing Communications field and specialising in Integrated Communication Strategy, Brand Management, and Dialogic Interventions, Nthabiseng engages her work as a Compassionate Health Communicator and Strategic Corporate & Creative Storyteller to change narratives.
Her goal is to advocate for the use of stories and storytelling to shift the social system by supporting individuals and organisations to; (1) change how they see themselves; (2) deepen their relationships with their communities, and; (3) facilitate lasting impact in their broader context.
During her career, she has worked across industries and sectors in PR & Communications, Hospitality, Education, Healthcare, and Finance. Throughout she has implemented various digital and traditional strategic marketing activities to support organisational development, strengthen stakeholder relationships, and meet mission-aligned objectives.
Ultimately, it is her belief that stories sew societies together, and as novelist Kazuo Ishiguro says, “stories are about one person saying to another: This is the way it feels to me. Can you understand what I'm saying? Does it also feel this way to you?” She insists that it is this depth of care and compassion toward relationships and stories that is required to truly shift our perspectives and re-imagine a narrative co-created between people who seek to understand one another wholly.
Dr. Mothomang Diaho - Founder and Medical Director: Spiral Aloe Health & Wellness
Dr. Mothomang Diaho: Founder of Spiral Aloe Health & Wellness | Host of Wellness Retreats | Gestalt Practitioner | 33+ Years in Preventative Medicine | Advocate for Lifestyle as Medicine
Dr. Mothomang Diaho brings over three decades of experience in preventative medicine, focusing on holistic wellness and lifestyle as medicine. She is a Gestalt practitioner and Cape Cod Methodology intervener, with a strong commitment to social justice and group intervention. Dr. Diaho facilitates leadership development at Stellenbosch Business School and serves as a Lifestyle Medical Advisor and Coach for the Future Professors Programme.
Holding a medical degree from the University of Adelaide, an MBA from Wits University, and a PMD from Harvard, she combines medical knowledge with business acumen. As a social entrepreneur, she co-founded TEACH South Africa and has held leadership roles at the Nelson Mandela Foundation. A Fellow of the African Leadership Initiative and the Aspen Global Leadership Network, Dr. Diaho is dedicated to improving societal wellbeing.
Alicia Stander - Education Specialist for Esse Skincare
Alicia Stander, the Education Specialist for Esse Skincare, lives in South Africa and is a proud mother of two. Her passion for skincare, education, science, and environmental conservation has driven her career and influenced her parenting. Committed to the skincare industry, Alicia advocates for understanding skin health and its environmental impact, emphasizing sustainable practices. She views her journey with Esse as a testament to combining personal passion with professional work. Dedicated to educating and inspiring globally, Alicia champions Esse’s unique approach to skincare.

Dr Juanita Kilian - Founder and CEO DrK Dermal Health
Dr Juanita Kilian, qualified as pharmacist at the University of North West, South Africa, in which thereafter she earned her Master’s in Derma-ceutical product development and Doctorate in Transdermal Delivery Technology at the University of London, School of Pharmacy.
Dr Kilian has engaged in the study of transdermal delivery systems and has made unique formulation discoveries, which had a profound influence on the development of the Dr K Dermal Health Care product range. Throughout her career, Juanita has worked extensively in South Africa, Africa, United Kingdom, Scandinavia, UAE, Russia, and various parts of Europe in which during this time has been actively researching and re-educating herself with the latest skin technology and Derma-ceutical chemistry information available.
Santé Wellness Retreat & Spa is an award-winning wellness retreat in the heart of the Western Cape winelands, offering luxury accommodation, a world-class day spa, conference facility, Health Optimizing Clinic, and Bio Energy Centre. Charlotte has been with Santé since its reopening six years ago. She is currently completing her PhD in Integrative Medicine and is dedicated to enhancing her clients’ overall health and wellbeing using the unique technologies and healing methodologies at Santé.
Payal Singh started her journey as a laboratory technician at Skin Rejuvenation Technologies in 2023. Driven by her passion and hard work, she moved into the position of Geneticist in 2024. She obtained her Bachelor of Science degree from the University of KwaZulu-Natal in 2021 and went on to study further at the University of Witwatersrand. She completed her Honours degree in 2022, specialising in Human Genetics where her project focused on analysing genetic variation in humans that could influence vaccine responses.
During her studies, she also worked at the University of Witwatersrand as a laboratory assistant and gained valuable experience. She is extremely passionate about genetic research and its application in various medical areas. She enjoys sharing her knowledge and uplifting others through her work. She strongly believes in making informed decisions and having a targeted approach in one’s healthcare journey.
Steve Uria - Wellness Director at Newmark Hotels & Reserves
Steve Uria integrates wellness principles across Newmark’s hospitality properties. A South African military specialist trainer, Steve has driven fitness innovation globally for over 30 years. He has trained Fortune 500 CEOs, athletes, and celebrities, and has been featured in major media outlets like CNN, ESPN, and Vogue USA. Steve’s entrepreneurial ventures include Eclipse One On One, BLAST 900, S.W.E.A.T 1000, and Switch Playground. Now, he works with Newmark to develop and implement new wellness concepts within the hospitality industry.
Tzvia Hermann - Founder and CEO, The Laser Beautique Group
Energetic, passionate, creative, and inspiring encapsulates who she is. Tzvia Hermann, is a multi-faceted award-winning entrepreneur, educator, author, philanthropist, marketer, creative, green lifestyle enthusiast, game changer, mom, and wife. She is the founder of The Beautique Group which includes a chain of aesthetic clinics (The Laser Beautique), an aesthetic and beauty academy (Beautique Academy), a distribution company (Beautique Brands), and BeauFam Games. Look out for BeauFam’s most recent launch, a proudly South African game called Flipping Queens.
You may recognize Tzvia from one of her passion projects, such as BeauRaze (South Africa’s first biodegradable razor), or you may have heard Tzvia at a
corporate or school function. Tzvia’s talks include various topics from creating a healthy culture and winning teams to recycling, inspiring green living & zero waste, body positivity, hygiene, skin concerns, embracing changes from puberty to pregnancy and pro-aging, as well as financial literacy. Teaching youth to understand, think, and plan for financial freedom is one of Tzvia’s favourite topics. Tzvia believes that real wealth is not about how much money you earn or have in the bank, but about the freedom and time you have to experience life, live to the fullest, and become a contributor in one’s community.
Tebogo Thoka - Founder and CEO, FabuHealth & Co, The Skin Whisperer
Tebogo Thoka, an independent aesthetic therapist, business consultant, and trainer with 14 years of industry experience and 10 years of running a successful, award-winning aesthetic clinic and wellness hub in Pretoria. I specialize in empowering business owners, beauty therapists, doctors, and nurses in the beauty and aesthetics field.
As the winner of the Spa Awards South Africa 2022 and one of Africa’s top 40 under 40 business elites in 2020, I bring a wealth of knowledge and recognition to my clients. I am also the co-author of “Life and Business Minds,” sharing insights into personal and professional success.
Known as The Skin Whisperer, I excel in advanced aesthetic training and business development, helping practitioners thrive both technically and commercially. My passion is to see my clients succeed and navigate the complexities of the beauty and aesthetics industry with confidence.
Esna Colyn - Chairperson of i-BLOOM Beauty
Esna Colyn is qualified as a Chartered Accountant in 1993 and is currently a member of SAICA. Esna gained substantial experience in banking, private equity and corporate finance before joining i-BLOOM Beauty, in May 2010 as the CEO. During her tenure at i-BLOOM Beauty Esna, realised that her true passion is to empower and inspire women. In 2022, Esna stepped down as CEO and assumed the role as Chairperson of i-BLOOM Beauty. This allows her to have sufficient time to pursue her true passions, additionally she enjoys to act as a Business Mentor to various young business entrepreneurs.
Mimmie Lancaster - Founder and Managing Director - Symmetry World
Mimmie Lancaster has been involved in the Spa and Wellness industry for 30+ years and in all this time has only missed 2 Les Nouvelles Esthetiques Congresses.
She successfully distributed Algologie and Pevonia to Spas in SA, Namibia & Mauritius. Mimmie was the 1 SA trainer to be become an International Professional skincare brands’ International trainer.
12 years ago Mimmie formed a new company Symmetry World, delivering independent advice to spas, salons and product houses. Symmetry World focuses on individual businesses assessing their needs according to their core values, character and market level in order to build and improve their companies’ performance. In 2022 her own ‘clean’, vegan friendly skincare line, I am me was launched to Wellness practitioners and a select few Spas.
Always actively involved in the industry Lancaster served as a board member of SAAHSP, a board member of the South African Spa Association and formed part of the committee who hosted the 2015 Cidesco World congress in Sandton. She is an active member of the Garden route Wellness Network.
Wellness facilities where she has played a significant role is Santé Wellness Retreat & Spa, Sterrekopje and Ousia Wellness Plettenberg Bay and a few ‘newbies’ to be revealed soon. Mimmie shares her passion for our industry with anyone who gives her a moment of their time, she is a passionate advocate for the professional therapist and continues to train therapists and leaders and therapists country wide.

BABOR: EXPERT SKINCARE. MADE IN GERMANY.
BABOR has been setting standards in cosmeceutical skin care for 6 decades. BABOR develops highly effective, customised solutions to meet the needs of every skin type. Confirmed by dermatological experts around the world.
Established in Aachen, Germany in 1956 - BABOR is an internationally leading brand of professional cosmeceutical products. BABOR is represented by distributors in more than 70 countries and has subsidiaries in Switzerland, Austria, the Netherlands, Belgium, South Africa, Australia, Kenya, Namibia, Zimbabwe, Sweden, Singapore, Canada and the USA.
With precision and cutting-edge performance being part of our core values, men and women around the world continue to experience confidence in their radiantly beautiful skin, thanks to BABOR's promise to deliver Expert Skincare. The BABOR Expert Method is a skincare system that creates the foundation of a routine focused on cleansing, treating, and protecting the skin.
BABOR continues to implement sustainable skincare solutions within all the products and packaging using clean sustainable ingredients and recycled materials.
For more information: https://za.babor.com babor.sa@babor.co.za
CSpa Aroma Wellness is the new generation aroma wellness inspired by the beauty of nature. A blend of aroma purist principles partnered with modern aromatherapy applications allow for a truly olfactory experience.
CSpa Aroma Wellness stems from a desire to provide African-inspired sensorial, luxurious treatments at affordable prices to ensure every person can embrace the spa/salon experience. CSpa Aroma Wellness offers FACE and BODY ranges to provide each client with a full wellness experience for both in-salon and homecare.
Made in Africa for Africa, is committed to protecting the environment and leaving a lasting and sustainable beauty legacy for future generations. With eco-friendly and recyclable packaging, CSpa Aroma Wellness ensures that the impact on the environment is minimised. The “clean formulation” based products are free of toxins, with naturally sourced ingredients.
For more information: http://www.cspa.co.za/ marketing@marinespadistributors.co.za
Optimal skin condition depends on the probiotic microbes living on and in it. Without these microbes, your skin can't perform its basic functions, and the rate of skin ageing increases sharply. Esse Skincare exists to keep your skin at its wild best. Esse uses organic biotechnology to create an environment on your skin that favours the growth of beneficial microbes, allowing your natural microbial diversity to return. Esse's products feature probiotics and prebiotics in organic formulations that help restore balance.
For more information: https://www.esseskincare.com/ info@esseskincare.com
Eyeing that figure-hugging dress or feeling determined to fit into your prebaby skinny jeans again? A fit, healthy body is the best fashion statement you can make. Our LipoSculpt product range can help you look your very best! Invest in your figure today and rediscover the beauty that's been hiding inside you all this time.
LipoSculpt is a nutricosmetic range of weight management products. Our innovative combination of high-quality products redefines weight management. The powerful ingredients deliver both internal and external solutions. Our products are scientifically formulated to combat weight, cellulite and water retention and support spot fat reduction.
LipoSculpt treats the core of your weight loss challenges. Supporting you to finally achieve your weight loss goals. LipoSculpt provides an effective weight management solution with proven, visible and lasting results.
For more information: https:// liposlim3in1.co.za liposculpt@slimskin.co.za
Discover Mama Mio's full range of pregnancy safe skincare and bodycare products. For every point of the journey, from bump to baby and beyond, these products provide pregnant women with the support they need for strong, healthy skin. These are the effective, unique and nourishing products created for Mamas, by Mamas. They have been designed to protect and soothe the skin from stretching throughout pregnancy. Made with the highest quality ingredients and packed with natural plant-based actives, these formulas have been crafted to always perform at their very best and deliver the results that Mamas can both see and feel.
For more information: www.mamaskincare.co.za orders@mamaskincare.co.za
Discover the essence of spa with the MatsiMela Spa Range. Our ecofriendly range is meticulously crafted to nurture both you and the environment, free from harsh chemicals and preservatives. From luxurious Body Butters to invigorating Salt Scrubs, our products offer pure indulgence for the senses.
Proudly supplied to top Salons and Spas nationwide and beyond, MatsiMela Spa is trusted by professionals and enthusiasts alike. Elevate your spa offering with our indulgent range.
Proudly South African
No animal testing
No harsh chemicals or preservatives
With the MatsiMela Spa range of products developed around this ethos of caring for yourself and the environment you can 'Be Well' and experience something truly amazing.
For more information: http://www.matsimela.co.za info@matsimela.co.za

Like the Nautilus Shell, @sixskincare has been designed with perfection in mind. At the same time, we strive for expansion and renewal in a way that not only keeps up with the latest in the industry but also creates stability in maintaining its excellence. Known as one of the top investment skincare brands in. South Africa, we are reliable in retaining advanced solutions that will suit your needs and exceed expectations. By being open to new concepts and doing extensive research in trusted procedures, we ensure that the fundamentals of younger looking skin are achieved.
PERFECTION is a steady state with SIX so we ensure time, effort and care are placed within all our products so that standards are upheld. With ongoing training, care in customer service and results-driven products, we expect nothing less than spotlessness, therefore at SIX, it is in our DNA to strive for flawless results.
RENEWAL is at the heart of our priorities as we grow with a fast changing environment. Where science meets nature, we seek the most effective active ingredients and at the same time, do our best to ensure a sustainable process.
EXPANSION is a constant and we develop by staying innovative and demanding the continuation of evolution in our products to ensure you have the best in care. In order to improve, change must be an ongoing process and we value combining that which works, with that which could work better.
For more informations: http://www.sixskincare.com info@thespaconsultants.co.za
THALGO: La Beaute Marine
Thalgo La Beaute Marine is one of the leading marine based cosmetic brand in the World. THALGO’s Holistic Vision of Beauty combines Efficacy and Well-Being
With over 50 years of history, the luxury brand Thalgo is investing in fundamental marine research, challenging the frontiers of aesthetic medicine and marine intelligence. Each Thalgo product is a genuine concentrate of marine effectiveness, created according to stringent standards of performance, total affinity with the skin and an ultimate sensory experience to offer Professional Excellence to the user. Led by science and marine research, performance and excellence stand at the core of each of Thalgo’s creations
Thalgo’s new ranges consist of marine active ingredients and neutral bases which are free of parabens, mineral oils, ingredients of animal origin, silicones or phenoxyethanol. This is part of the Clean Beauty Pact. Thalgo’s packaging has also been altered for a more eco-friendly design, where primary containers are chosen for their recyclability and themselves made of recycled materials.
THALGO is represented in over 90 countries worldwide, providing a strong international presence in over 500 Prestigious Hotel Spas.
For more information: http://www.thalgo.co.za marketing@marinespadistributors.co.za
THE SAUNA & STEAM GUY
“ We have been manufacturing and installing saunas, steam rooms and other spa equipment for just over 14 years. We also install Rasul Rooms, Vichy showers, Mist rooms, Sensation showers, Hydro baths and Jacuzzi’s.
We are affiliated with Sauna King, a Cape Town based Sauna and Steam specialist and together we have supplied and installed our equipment in some of the biggest Hotels, Gyms, Spas and private homes, not only in South Africa but also in many of our neighbouring countries.
With combined experience of the spa industry and manufacturing and installing the various spa equipment of over 50 years, we strive to deliver the best quality saunas and steam rooms in South Africa. We deal with some of the biggest names in the industry, TYLO in Sweden, another leader in manufacturing their own sauna heaters and steam generators of only the highest quality, Steamflo, a true South African company who manufactures world class sauna heaters and steam generators using only the best quality material in the process. SAWO, a company based in Finland with a range of top-quality heaters and steam.”
For more information: http://www.saunaandsteam.co.za info@saunaandsteam.co.za
The Laser Beautique is a new-age franchise dedicated to ensuring clients live smoothly ever after. Specializing in skin treatments and permanent hair removal, they combine groundbreaking technology with intense training to deliver magical results. From eliminating unwanted hair to rejuvenating skin without surgery, The Laser Beautique inspires self-confidence and offers exceptional customer service.
For more information: www.thelaserbeautique.co.za info@thelaserbeautique.co.za
Since the earliest time, Africa's original inhabitants lived in harmony with nature. Inspired by the wisdom of traditional healers' use of exotic scents and herbs with well-reputed healing properties and in celebration of Africa's rich heritage and her connection with life, TheraNaka® is a range exploding with earthy richness and renewed life. From heavenly aromas to herbal purity this unique range is a mesmerising and innovative body and sensesoothing safari, replicating the earthy scents and the awe-inspiring wonder of this most profound continent.
The extraordinary journey of designing TheraNaka® is rooted in one woman's inspiration to create a range using Africa's natural active botanicals with a vision to support rural communities, sustainable production and protection of the environment for a better future. This unique South African product range was established and came to life in 2005 after extensive research, delivering formulations rich in natural healing and soothing properties, where the finest African plant extracts and traditional rituals unlock the beauty of Africa. At the heart of the TheraNaka® range are therapeutic essential oils that rejuvenate and restore balance to the body and mind. Each collection is meticulously formulated with a unique blend of carefully interwoven essential oils for a collective full body synergistic effect.
“Because our aim is to ensure that the body and soul are treated in harmony, we promise to continue our passion of transforming the treasures hidden in the captivating aromas of Africa, in to a truly authentic African journey.”
For more informations: http://www.theranaka.co.za info@ttheranaka.co.za


By Dr Nadine de Freitas - Les Nouvelles Esthetiques
In 2024, the global wellness industry is poised for substantial growth, projected to leap from $5.6 trillion to $8.5 trillion by 2027. However, this surge isn't just about economic figures-it reflects a profound evolution in how people approach wellness, characterized by two distinct paths: "hardcare" and "softcare," as identified by the Global Wellness Summit (GWS). These paths underscore a fundamental shift in consumer preferences: a choice between advanced, medical-driven solutions and holistic, emotionally and socially centered practices.
Advancements in Longevity and Medical Wellness
Hardcare wellness embraces cutting-edge medical technologies and treatments. Longevity clinics epitomize this trend by offering advanced diagnostics and interventions such as stem cell therapies. These clinics cater not only to those seeking to prevent health issues but also to individuals proactively extending their lifespan and enhancing overall health. The integration of medical advancements into wellness reflects a shift towards a scientific, datadriven approach to personal wellbeing.
Pharmaceutical Interventions for Wellness
Another hallmark of "hardcare wellness" is the rise of pharmaceutical solutions, particularly in areas like weight management. These medications provide alternatives to traditional lifestyle changes for individuals struggling with obesity and related health challenges.
Technological Innovation in Health and Fitness:
Technology plays a pivotal role in "hardcare wellness," revolutionizing how individuals manage
their health and fitness. From wearable devices to AI-driven diagnostics, these innovations enable continuous monitoring of health metrics and informed decision-making about wellbeing. This precisionoriented approach enhances the efficiency of healthcare delivery and empowers individuals to take proactive steps towards better health outcomes.
Reclaiming Ancient and Holistic Wellness Practices
In contrast to the high-tech allure of "hardcare," "softcare wellness" focuses on simplicity, authenticity, and emotional resonance in wellness. There is a notable cultural shift, especially among younger generations and women, towards embracing ancient practices that prioritize social and emotional wellbeing over commercialized wellness trends. This includes a resurgence of interest in pilgrimage journeys, offering opportunities for spiritual reflection and communal connection away from the pressures of modern life.
Within "softcare wellness," there is a concerted effort to redefine emotional wellness beyond superficial ideals. This involves acknowledging and addressing mental health issues through supportive communities, mindfulness practices, and accessible therapeutic resources. The emphasis is on nurturing resilience and fostering genuine emotional connections - a response to the growing recognition of mental health as integral to overall wellbeing.
Addressing Environmental Challenges
Climate-adaptive wellness emerges as a pivotal component of "softcare," addressing pressing
environmental issues. Practices and innovations in this domain aim to mitigate the impact of climate change on personal health and promote sustainability. From eco-friendly products to community-driven initiatives, these efforts align personal wellness with planetary health, advocating for a holistic approach to global challenges.
Convergence and the Future of Wellness Thinking
The dichotomy between "hardcare wellness" and "softcare wellness" reflects the diverse needs and preferences within today's wellness landscape. While "hardcare" emphasizes technological advancement and precision medicine, "softcare" prioritizes human connection, emotional authenticity, and sustainable living practices. Both approaches coexist within a segmented market that caters to varying demographic and cultural demands.
Looking ahead to 2024 and beyond, the future of wellness will likely witness continued innovation and integration across these dual perspectives. Technological advancements will further enhance "hardcare" offerings, making healthcare more personalized and accessible. Simultaneously, the "softcare" movement will advocate for inclusive and sustainable practices that nurture individual wellbeing and community resilience.
Ultimately, the convergence of promises a balanced approach to wellness - one that integrates scientific rigour with humanistic values. This holistic vision seeks to promote comprehensive health and happiness in an increasingly interconnected and complex world, bridging the gap between medical progress and the timeless pursuit of wellbeing.

By Sophie Meyer - Les Nouvelles Esthetiques, France

The spa industry is experiencing a profound transformation marked by a return to simplicity. This shift mirrors a growing client preference for straightforward treatment options, effective skincare products, and transparent service offerings that enrich overall spa experiences. As spas navigate this evolving landscape, they are embracing customized approaches to address individual wellness needs while creating distinctive, signature treatments to set themselves apart in a competitive market.
Today's spa clientele increasingly favour clear and concise service menus that streamline choices and elevate their overall spa journey. This trend not only enhances client satisfaction but also boosts sales conversions. By offering personalized services tailored to specific concerns - such as custom regimens based on individual skin types-spas can ensure both client contentment and operational efficiency.
The embrace of simplicity encompasses several critical elements:
Transparent Service Menus: Clients appreciate service menus that clearly outline treatment options, benefits, and expected outcomes. Spas benefit from avoiding technical language and simplifying descriptions, empowering clients to make informed decisions about their wellness routines.
Effective Skincare Products: There is a noticeable preference for skincare products that are uncomplicated yet highly effective. Clients seek formulations with clinically proven ingredients targeting hydration, anti-aging, or sensitivity concerns.
Streamlined Treatment Protocols: Simplifying
treatment protocols ensures consistency and enhances the client experience. From booking appointments to post-treatment care, spas optimize processes to deliver seamless service that meets client expectations.
As spas continue to embrace simplicity, they redefine the standard of care in the wellness industry by focusing on clarity, effectiveness, and personalization to cater to today's discerning clientele.
I underscore the significance of developing a distinctive signature treatment to stand out in a competitive market. A signature treatment should embody the spa's unique philosophy, showcase its expertise, and deliver exceptional results that resonate with clients seeking specialized care.
Blend of Techniques and Trends: Integrating various techniques - from traditional spa rituals to cutting-edge technologies - creates a holistic and multifaceted treatment experience. This blend allows spas to cater to diverse client preferences while showcasing versatility and innovation.
Personalized Touches: Customizing treatments to meet individual needs enhances client satisfaction and ensures a memorable spa experience. Whether adjusting product formulations or incorporating specific massage techniques, personalization adds value and reinforces the spa's commitment to client well-being.
Unique Selling Proposition (USP): A signature treatment should articulate the spa's USP and differentiate it from competitors. This could involve exclusive ingredients, proprietary techniques, or a
thematic approach aligned with the spa's brand identity.
Client Education and Engagement: Educating clients about the benefits and unique aspects of the signature treatment cultivates enthusiasm and encourages repeat visits. Engaging clients in the treatment process and requesting feedback fosters a sense of partnership and enhances overall satisfaction.
A well-conceived signature offering serves as a cornerstone of the spa's brand identity, reinforcing its reputation as a leader in personalized and effective skincare solutions.
In a competitive market flooded with generic cosmetic treatments, personalized signature services are indispensable for elevating a spa's reputation and fostering long-term client loyalty.
Coupled with Continuous Innovation: Staying current with industry trends and technological advancements enables spas to innovate and evolve their service offerings. Introducing new treatments, upgrading equipment, and incorporating feedback from clients and staff contribute to a dynamic and forward-thinking spa environment.
As the spa industry evolves, integrating advanced technologies with timeless holistic practices ensures that spas remain at the forefront of innovation while delivering unparalleled experiences that resonate deeply with clients. By staying true to their commitment to simplicity and excellence, spas can navigate challenges, seize opportunities, and thrive in an increasingly competitive and discerning market.

By Dr Nadine de Freitas - Les Nouvelles Esthetiques

When we think of innovation, it's often associated with cutting-edge technologies and groundbreaking techniques. However, true innovation involves introducing something new, which can encompass a wide range of changes and creative approaches. But, let's explore how you can stimulate creativity and generate new ideas without straining your cash flow.
Embracing the trend of personalized care through thorough diagnosis can significantly enhance your service offerings without requiring substantial investment. Consider implementing diagnostic tools across various aspects of beauty and wellness:
Skin Diagnosis: Develop a questionnaire-based skin assessment tool to understand your client's specific needs and concerns before facial treatments. This not only personalizes their experience but also helps in recommending suitable products and treatments.
Wellness Assessment: Conduct a comprehensive assessment before massages or body treatments to gauge your client's physical and mental state. Inquire about existing conditions, stress levels, and skincare habits to tailor treatments effectively.
Body Care Diagnosis: Prioritize discussions on contraindications and lifestyle habits during body care treatments. This holistic approach allows you to offer personalized recommendations, including skincare products and dietary supplements.
Implementing these diagnostic practices not only
streamlines your process but also demonstrates your commitment to understanding and addressing your clients' unique needs.
Your hands are your most valuable tools. Investing in mastering manual techniques not only enhances your service repertoire but also aligns with current trends favoring hands-on approaches:
Expand Your Massage Techniques: Explore less common techniques such as Lomi-Lomi, Ayurvedic, or Balinese massages. These ancient methods can provide unique selling points and differentiate your offerings in the competitive spa market.
Revive Forgotten Techniques: Revisit old training materials and protocols. Techniques like shiatsu, which may have been overlooked, can be reintroduced as novel treatments, appealing to clients seeking diverse and authentic spa experiences.
Introduce ephemeral treatments that add excitement and variety to your menu without long-term commitments:
Limited-Time Protocols: Create exclusive treatments available for short periods, such as a special salt scrub or a unique facial incorporating handmade ingredients. This strategy encourages repeat visits and generates buzz around your spa.
Signature Treatments: Develop signature treatments, like a facial combined with scalp, hand,
and foot massages. These personalized experiences not only delight customers but also elevate your brand as a provider of bespoke spa services.
Amidst all innovations, maintaining authenticity is crucial to preserving your spa's core values and expertise:
Consistency in Expertise: Focus on what you excel at and avoid chasing trends that don't align with your brand identity. Your expertise and genuine passion for spa and wellness will resonate more with clients than fleeting fads.
Continuous Improvement: Regularly review and refine your customer journey. Small enhancements in customer service and experience can lead to significant gains in client satisfaction and business growth.
Innovation in your spa business doesn't have to break the bank. By leveraging creativity, embracing personalized care, mastering manual techniques, and enhancing client experiences, you can differentiate your spa and attract a loyal clientele.
Remember, the key is to innovate strategically while staying true to what makes your spa unique. This approach not only strengthens your market position but also fosters lasting relationships with your clients based on trust and satisfaction.

By Jacoline Wentzel, Managing Director of The Spa Warehouse

In the dynamic landscape of spa design, the confluence of technology, advanced wellness solutions, consumer preferences, and interior trends demands constant innovation.
The essence of a spa's allure often lies in its ability to offer a serene escape from the bustling world outside. In Africa, spas are uniquely positioned to capitalize on breathtaking vistas, such as the iconic Table Mountain, the expansive African bush, or the majestic winelands. These natural panoramas provide an irreplaceable backdrop that enhances the guest experience in a way that until recently was thought to be inimitable. However, advancements in digital technology have introduced a new frontier in spa design. Companies like Wellscape are revolutionizing the industry by crafting hyper-realistic, AI-generated environments that replicate the tranquility of nature, offering an immersive experience even in the absence of direct natural surroundings.
Elevating the spa experience further involves reimagining every aspect of the architectural space. The ceiling, often overlooked, holds vast potential for creative expression. By incorporating elements such as textured cladding, reflective surfaces, polished shapes, or textured plaster, designers can transform this blank canvas into a source of visual intrigue, warmth, and atmosphere. This attention to detail can turn a simple walk through a corridor or the repose during a treatment into an opportunity to engage with the space in a new and meaningful way.
In response to the increasing pace of modern life, there is a growing desire for spaces that allow for digital detoxification. The spa of the future is envisioned as a sanctuary free from the incessant pull of technology. For those apprehensive about completely disconnecting, the integration of biophilic design principles in designated tech-free pause areas can offer a compromise. These spaces, infused with elements of nature, provide guests with a place to retreat and rejuvenate their minds, bridging the gap between the digital and natural worlds. The challenge
for spa designers is to harmonize these diverse elements-views, ceilings, and pause areas-into a cohesive environment that resonates with the evolving needs and desires of spa guests, creating a haven of wellness that stands out in an ever-competitive landscape.
Japandi, a design trend that marries the minimalist elegance of Japanese aesthetics with the functional simplicity of Scandinavian design, is gaining popularity for its serene and uncluttered approach to spaces. Originating in the 1860s, this style emphasizes a calming palette of neutral and earthy tones, complemented by the occasional splash of green to reflect the natural world. Furniture pieces in Japandi interiors are characterized by their clean lines and soft, rounded shapes, promoting a sense of tranquility and comfort. The use of light woods and discreet storage solutions further enhances the minimalist ethos, ensuring that each item within the space has both a purpose and a place. This design philosophy not only creates visually appealing environments but also supports a lifestyle that values mindfulness and the beauty of simplicity. Hence will be more and more popular in the future of spa design.
The evolution of luxury brands into the wellness and cultural sectors represents a significant shift in consumer engagement strategies. By integrating their identity into the fabric of lifestyle and wellness, these brands are transcending traditional boundaries and forging deeper connections with their clientele. The emergence of concept spas, such as those created by Dior and Evian, exemplifies this trend, offering an immersive experience that aligns with the brand's aesthetic and values.
These collaborations are not merely about extending a brand's presence; they are about creating a narrative that resonates with the consumer's desire for authenticity and shared values. The strategic placement of brand elements within the spa environment, from the design motifs to the choice of amenities, is a deliberate effort to craft an atmosphere that reflects the brand's heritage and ethos. The Dior spa at Cheval Blanc in Paris, for instance,
is not just a space for relaxation but a testament to the brand's commitment to elegance and craftsmanship. Similarly, the Evian Spa's design, inspired by the natural lifecycle of its famed mineral water, speaks to the brand's dedication to purity and natural beauty.
These spaces become extensions of the brand's story, inviting consumers to partake in a lifestyle that is both aspirational and attainable. As luxury brands continue to innovate in this space, we can anticipate a new era where wellness and culture are not just adjacent to the brand but are integral to its identity.
The integration of medical wellness into the realm of spa retreats is a burgeoning trend, reflecting a shift towards a more holistic approach to health and luxury. Renowned establishments like Palazzo Fiuggi and Clinique La Prairie exemplify this successful melding of medical expertise with the tranquility of spa environments. To meet the rising demand, spa designs are evolving to incorporate medical, nutritional, and genetic services. This necessitates the creation of private consultation areas, dedicated entrances to ensure confidentiality, and specialized zones equipped for treatments such as IV therapy, cryotherapy, and laser therapies. The design must balance clinical functionality with the serene ambiance expected of a spa, ensuring that guests can experience seamless, state-of-the-art care within a restful setting.
In the burgeoning field of wellness, the design of a spa facility is a critical factor that can significantly influence its success. As the spa industry integrates more deeply with the global preventative health movement, it's essential to envision a space that not only provides relaxation and rejuvenation but also aligns with the holistic health goals of its clientele. Thoughtful planning, which includes understanding the end goal and meticulously designing each element to contribute to the overall experience, ensures that a spa can meet the evolving demands of wellness enthusiasts.


Between 2020 and 2030, the population aged 75 to 84 is projected to increase significantly, emphasizing the need to support clients in mastering the art of well Ageing.
In recent years, the concept of Well Ageing has transcended mere trendiness to become a profound philosophy guiding the spa and wellness industry. Unlike conventional anti-ageing approaches that focus solely on superficial treatments and quick fixes, Well Ageing represents a paradigm shift - a holistic and proactive approach to ageing that emphasizes comprehensive health, mindfulness practices, and long-term well-being. This transformative concept resonates deeply with individuals seeking not just youthful appearances but a profound sense of vitality and resilience across all dimensions of their lives.
Well Ageing fundamentally challenges the traditional narrative of ageing as a process to be resisted or concealed. Instead, it encourages individuals to embrace ageing as a natural part of life's journey, empowering them to make informed choices that support their overall health and vitality. At its core, Well Ageing promotes strategies that foster physical, emotional, and spiritual well-being, aiming for a balanced and fulfilling life at every age.
Central to the concept of Well Ageing is the integration of holistic health principles into beauty and wellness practices. This holistic approach acknowledges the interconnectedness of various aspects of well-being-physical, mental, emotional, and spiritual-and recognizes that nurturing these dimensions collectively contributes to a more vibrant and youthful appearance.
Holistic health in Well Ageing encompasses:
• Nutritional Support: Recognizing the role of diet in skin health and overall vitality. Encourageing balanced nutrition that supports cellular regeneration and resilience.
• Mindfulness and Stress Management: Incorporating mindfulness practices such as meditation, yoga, and relaxation techniques to mitigate stress, which accelerates ageing processes.
• Physical Fitness: Promoting regular physical activity to enhance circulation, improve muscle tone, and support overall cardiovascular health, which in turn benefits skin appearance.
• Sleep Optimization: Emphasizing the importance of quality sleep in cellular repair, hormone regulation, and cognitive function, all crucial for maintaining youthful vitality.
Unlike conventional anti-ageing treatments that often target wrinkles and fine lines superficially, Well ageing advocates for deeper, more holistic interventions. This may include:
• Bespoke Skincare Regimens: Tailoring skincare routines to individual skin types, concerns, and lifestyles, using products rich in antioxidants, vitamins, and botanical extracts to nourish and protect the skin.
• Non-Invasive Cosmetic Procedures: Embracing non-surgical treatments like laser therapies, microneedling, and dermal fillers when appropriate, to enhance skin texture and appearance without invasive surgery.
• Alternative Therapies: Incorporating complementary therapies such as acupuncture, herbal medicine, and aromatherapy to support overall well-being and address specific ageingrelated concerns.
Well Ageing places a strong emphasis on personalized care and client education. By fostering a deeper understanding of the ageing process and the factors that influence it, spa professionals and wellness practitioners can empower their clients to make informed choices about their health and skincare routines. This educational aspect not only enhances client satisfaction but also builds trust and loyalty over time.
At its essence, Well Ageing celebrates longevity as a byproduct of holistic health practices rather than a mere extension of youthful appearances. It encourages individuals to redefine ageing not as a decline but as an opportunity for personal growth, resilience, and self-discovery. By adopting Well Ageing principles, individuals can cultivate a positive outlook on ageing, embracing each stage of life with grace and confidence.
Looking ahead, the future of Well Ageing promises continued innovation and evolution. As advancements in skincare technology, nutrition science, and holistic therapies continue to unfold, spa professionals and wellness practitioners will have increasingly sophisticated tools and techniques at their disposal to support clients on their Well Ageing journey.


In the face of economic challenges, international consumers maintain a steadfast commitment to their beauty regimens, employing strategic approaches to optimize their spending. Here's an in-depth exploration of their purchasing behaviours across various beauty categories:
French consumers exhibit a pragmatic approach to beauty expenditures, with a significant majority prioritizing affordability in their monthly budgets. According to recent data, 84% allocate less for nail care, underscoring a preference for cost-effective solutions. Similarly, 76% limit spending on body care products, while 75% and 70% respectively adhere to it for hair care and skincare essentials. Makeup and perfumes also see substantial budgetary limitations, with 69% and 57% of consumers respectively opting to spend conservatively.
A substantial portion of French consumers actively engage in price comparison and cost-saving measures. Notably, 46% of shoppers meticulously compare prices across brands and retailers to secure the best deals. Another 22% actively seek out more affordable alternatives, while 26% regularly search promotional discounts before making their final purchase decisions. These behaviours highlight a persistent effort to balance quality and cost-effectiveness in their shopping routines.
In recent years, there has been a notable shift among international consumers towards cleaner and sustainable beauty practices. This trend is characterized by a heightened preference for products that prioritize ethical sourcing, organic ingredients,
By Sophie Meyer - Les Nouvelles Esthetiques, France
cruelty-free formulations, and recyclable packaging.
Key insights include:
Ethical Ingredients: A significant majority (60%) of consumers prioritize beauty products that feature ethically sourced ingredients. Additionally, 40% prefer products made with organic ingredients, reflecting a growing awareness of environmental and health considerations.
Sustainability Initiatives: Approximately half of the surveyed population (50%) actively seek out crueltyfree products, and 40% emphasize the importance of recyclable packaging in their purchasing decisions. This underscores a collective commitment to reducing environmental impact and supporting sustainable practices within the spa industry.
Transparency and Consumer Preferences: Transparency remains a critical factor for 35% of consumers, who actively seek greater disclosure from cosmetics brands regarding their sourcing and production practices. Moreover, 33% believe that sustainable practices should be standard across the industry, signaling a demand for accountability and ethical responsibility among brands.
The concept of masculine beauty is evolving, with an increasing acceptance of gender-neutral products and skincare routines.
Inclusive Skincare: A significant majority (85%) of male respondents use between 1-3 skincare products regularly, with motivations ranging from enhancing confidence (39%) to finding enjoyment in their skincare routines (36%).
and Makeup Trends
Preference for Minimalist and Natural Beauty
International consumers exhibit a preference for minimalist skincare and makeup routines, opting for products that offer effective ingredients and a natural finish.
Key trends include:
Holistic Skincare Solutions: There is a notable preference for skincare products enriched with potent ingredients such as peptides, vitamin C, and hyaluronic acid. Additionally, the popularity of skincare supplements continues to grow, promoting a holistic approach to achieving radiant and healthy skin.
Natural Makeup Aesthetics: Minimalist makeup styles that accentuate natural beauty features prominently among French consumers. This trend emphasizes a luminous complexion, radiant skin, and voluminous lashes, underscoring a preference for enhancing natural beauty rather than masking it with makeup.
While French consumers exhibit distinct preferences for affordability, sustainability, and minimalist beauty, these trends resonate on a global scale as well. Across various international markets, there is a growing demand for budget-friendly beauty options, cleaner formulations, inclusivity in skincare products, and a shift towards gender-neutral beauty standards. Brands worldwide are responding to these evolving preferences by enhancing transparency, offering ethical choices, and promoting natural beauty ideals in their product offerings.
These insights not only provide a comprehensive understanding of current trends but also underscore the dynamic nature of consumer preferences within the evolving spa industry landscape.



In recent years, the spa and wellness industry has undergone a remarkable transformation, moving beyond traditional relaxation treatments to embrace a holistic approach that integrates ancient wisdom with modern innovation. This evolution has given rise to integrative spa therapies, which blend mindfulness practices, movement therapies, culinary experiences, artistic expression, sound therapies, and innovative spa treatments. These holistic offerings not only enrich the guest experience but also empower individuals to embark on journeys of selfdiscovery and optimal health, and redefine the future of wellness hospitality.
Integrative spa therapies represent a departure from conventional spa treatments by incorporating diverse modalities that cater to the holistic well-being of guests. Rooted in ancient healing traditions from around the world, these therapies recognize the interconnectedness of mind, body, and spirit. By combining centuries-old practices with contemporary wellness innovations, integrative spas offer a comprehensive approach to health and wellness that resonates with modern spa-goers seeking more than relaxation.
Mindfulness Practices: At the heart of integrative spa therapies are mindfulness practices such as meditation, breathwork, and guided visualization. These techniques promote mental clarity, stress reduction, and emotional balance, laying the foundation for deeper healing and self-awareness.
Movement Therapies: Integrative spas often incorporate movement therapies such as yoga, Tai
By Dr Nadine de Freitas - Les Nouvelles Esthetiques
Chi, and Qi Gong. These practices not only enhance flexibility and physical strength but also support energy flow throughout the body, promoting overall vitality and well-being.
Culinary Experiences: Nutrition plays a crucial role in holistic wellness. Integrative spas offer culinary experiences that emphasize organic, locally sourced ingredients and mindful eating practices. Cooking classes, nutritional consultations, and farm-to-table dining experiences educate guests about the connection between food and well-being.
Artistic Expression: Creative arts therapies, including painting, pottery, and music therapy, encourage self-expression and emotional release. These activities stimulate the senses, foster creativity, and provide a therapeutic outlet for guests to explore their inner worlds.
Sound Therapies: Sound healing practices, such as Tibetan singing bowl sessions and sound bath experiences, utilize vibrational frequencies to promote relaxation, balance energy centers (chakras), and enhance mental clarity. These therapies facilitate deep states of relaxation and inner harmony.
Innovative Spa Experiences: Integrative spas incorporate innovative treatments that combine traditional spa rituals with cutting-edge technologies. Examples include, from customized wellness programs, hydrotherapy treatments, watsu, floatation pools, through to pilgrimages and digital detox retreats.
The evolution of integrative spa therapies sets a new standard for excellence in wellness hospitality. By
embracing a holistic approach that integrates ancient wisdom with modern science, spas are positioned to meet the diverse needs of today's discerning guests. Beyond pampering and relaxation, integrative spas serve as catalysts for personal transformation and empowerment. They foster environments where guests can reconnect with themselves, cultivate mindfulness, and embark on journeys toward optimal health and vitality.
As integrative spa therapies continue to evolve, they promise to redefine the future of wellness by expanding access to comprehensive, personalized wellness experiences. Trends indicate a growing demand for integrative therapies that integrate advanced technologies, evidence-based practices, and sustainable principles.
Integrative spa therapies represent a transformative shift in the spa and wellness industry, blending ancient wisdom with modern innovation to foster holistic well-being and personal transformation. By embracing mindfulness practices, movement therapies, culinary experiences, artistic expression, sound therapies, and innovative spa treatments, integrative spas enrich the guest experience while empowering individuals to embark on journeys of self-discovery and optimal health. This holistic approach not only meets the diverse needs of spagoers but also sets a new standard for excellence in the realm of wellness hospitality. As integrative spa therapies continue to evolve, they promise to redefine the future of wellness, offering profound benefits for both guests, spas and practitioners alike.


In the realm of wellness, a new frontier has emergedone that not only promises to extend the quantity of life but also to enhance its quality. This burgeoning sector, often referred to as longevity or anti-ageing, represents a convergence of medical advancements and holistic wellness practices. As of 2024, it stands as one of the fastest-growing genres within the broader wellness industry, attracting entrepreneurs, researchers, and health enthusiasts alike.
Longevity as a concept encompasses strategies, treatments, and lifestyles aimed at extending human lifespan and promoting healthier ageing. What distinguishes it from traditional medical approaches is its holistic and preventive focus. Rather than solely targeting disease treatment, longevity seeks to optimize health parameters before ailments manifest. This proactive approach includes interventions such as nutritional optimization, hormone therapies, genetic testing, and personalized lifestyle prescriptions tailored to individual genetic predispositions and biomarkers.
The roots of modern longevity can be traced to scientific breakthroughs in genetics, biotechnology, and regenerative medicine. Advances in understanding the ageing process at a molecular level have paved the way for innovative therapies that not only address age-related decline but also aim to reverse it. From telomere lengthening to senolytic therapies that target and eliminate senescent cells, the field of longevity is characterized by its pioneering spirit and quest for innovative solutions.
At its core, the longevity industry represents a fusion of medical and wellness paradigms. Medical institutions and research labs collaborate with wellness centers and spas to offer integrated longevity programs. These programs often combine medical diagnostics, such as comprehensive blood panels and genetic testing, with holistic wellness practices like personalized nutrition plans, mindfulness training, and physical fitness regimens.
The integration of medical expertise with wellness
By Dr Nadine de Freitas - Les Nouvelles Esthetiques
practices not only enhances the efficacy of treatments but also enriches the overall client experience.
Individuals seeking longevity interventions are increasingly drawn to facilities that offer a comprehensive approach-one that addresses both the physiological and psychological aspects of ageing. This synergy has spurred the rapid growth of specialized clinics and retreats dedicated to longevity, catering to a diverse clientele ranging from health-conscious millennials to active seniors.
Several key trends are shaping the trajectory of the longevity industry in 2024 and beyond:
• Personalized Medicine: Advances in genetic testing and biomarker analysis enable practitioners to tailor interventions to an individual's unique genetic makeup and health profile. This personalized approach maximizes treatment efficacy and minimizes adverse effects, setting a new standard for precision medicine.
• Regenerative Therapies: Stem cell treatments, growth factors, and regenerative techniques are gaining traction as potential anti-ageing therapies. These interventions aim to rejuvenate tissues, improve organ function, and mitigate age-related decline, offering promising results in clinical trials and realworld applications.
• Nutritional Optimization: The role of diet in promoting longevity has garnered significant attention, with personalized nutrition plans emphasizing nutrient-dense foods, intermittent fasting, and dietary supplements. Nutritional interventions not only support overall health but also contribute to cellular repair and metabolic balance.
• Mind-Body Interventions: Mindfulness practices, stress management techniques, and cognitive training are integral components of longevity programs. These interventions not only enhance mental resilience but also influence physiological processes linked to ageing, such as inflammation and immune function.
• Technological Innovations: Wearable devices, health apps, and telemedicine platforms facilitate
remote monitoring and personalized coaching, enhancing accessibility to longevity services. Virtual consultations and digital health records streamline patient / client care and foster ongoing engagement in wellness practices.
The rise of longevity as a prominent sector within the wellness industry presents opportunities and challenges for businesses and consumers alike. For entrepreneurs and investors, entering the longevity market requires navigating regulatory frameworks, sourcing cutting-edge technologies, and cultivating partnerships with healthcare providers. Innovations in longevity therapies and wellness protocols drive market differentiation and consumer demand, positioning early adopters for growth and scalability.
Consumers, on the other hand, benefit from expanded access to evidence-based longevity interventions and personalized wellness services. The shift towards proactive health management empowers individuals to take charge of their ageing journey, investing in strategies that optimize longevity and enhance vitality. As awareness of longevity benefits spreads, demand for integrative wellness experiences - from luxury retreats to communitybased clinics - continues to escalate, reshaping the landscape.
Looking ahead, the future of longevity holds promise for further innovations in biotechnology, artificial intelligence, and personalized medicine. Collaborations between academia, industry, and regulatory bodies will drive research advancements and facilitate the translation of scientific discoveries into clinical practice. By fostering a multidisciplinary approach to ageing, the longevity industry stands poised to redefine the boundaries of human health and wellness in the 21st century.
By embracing the principles of prevention, personalization, and integrative care, the longevity sector has the opportunity to shape a future where ageing is synonymous with vitality, resilience, and longevity.

Talent management in the spa industry is not just a necessity but a critical component for achieving excellence and sustaining a competitive advantage.
From recruitment strategies that attract top-tier professionals to designing competitive compensation structures and embracing innovative talent management practices, spa professionals navigate a complex landscape to foster growth and success.
Recruiting talented individuals forms the cornerstone of a successful spa operation. Innovative recruitment methods are essential to attract skilled professionals who can deliver exceptional guest experiences.
Here are effective strategies to consider:
Utilize AI-driven platforms for candidate sourcing and assessment. These tools streamline


Implement performance bonuses and commission structures tied to individual and team goals. Such incentives not only encourage excellence in service delivery but also motivate employees to achieve outstanding results, driving overall spa performance.
Establish robust recognition programs that celebrate achievements and milestones. Beyond monetary incentives, consider nonfinancial rewards like employee of the month awards or exclusive spa service discounts to boost morale and foster a positive work environment.
Innovation in talent management practices distinguishes spas and cultivates a supportive, dynamic workplace. Consider these innovative approaches:
By Sophie Meyer - Les Nouvelles Esthetiques, France
the recruitment process by identifying candidates who not only possess the requisite skills but also align with your spa's culture and values.
Implement inclusive hiring practices to cultivate a diverse team reflective of your spa's clientele. Diverse teams enhance creativity and innovation while improving overall customer satisfaction by offering a broad range of perspectives and experiences.
Forge partnerships with local cosmetology and wellness schools to cultivate future talent. Establish internship programs and collaborative initiatives to identify and train potential employees, ensuring a steady influx of skilled professionals.
Compensation is pivotal in attracting and retaining top spa talent. Designing competitive compensation structures goes beyond salary to encompass various elements that contribute to employee satisfaction and productivity:
Offer competitive base salaries complemented by comprehensive benefits such as medical aid, wellness programs, and retirement plans. These benefits support employees' overall wellbeing and financial security.
Provide opportunities for professional growth through training workshops, certifications, and mentorship programs. Encourage continuous learning and skill enhancement to support career progression and job satisfaction among employees.
Offer flexible scheduling options and remote work opportunities where feasible. Flexibility accommodates work-life balance needs, enhances employee satisfaction, and contributes to a positive organizational culture.
Conduct regular surveys to gather feedback on workplace satisfaction, communication effectiveness, and opportunities for improvement. Utilize insights to refine talent management strategies and address employee concerns proactively.
Effective spa talent management is fundamental to achieving spa excellence. By implementing innovative recruitment strategies, designing competitive compensation structures, and embracing cutting-edge talent management practices, spas can attract, retain, and develop top-tier talent. Whether enhancing recruitment efforts, revamping compensation packages, or innovating in talent development, leveraging these strategies optimizes your spa's talent strategy, fostering success and excellence in the competitive spa industry.

By Dr Nadine de Freitas - Les Nouvelles Esthetiques

In recent years, the concept of wellness has transcended traditional boundaries, extending its influence into the realm of real estate. Today, property developers are increasingly prioritizing the health and well-being of occupants, revolutionizing how buildings are sourced, designed, and operated across residential and commercial sectors. Hence the explosion of real estate wellness.
Real estate wellness is experiencing a paradigm shift, driven by several key trends that are reshaping the industry landscape:
Modern properties are increasingly designed to foster social interactions and combat social isolation. Communal spaces, shared amenities, and thoughtful layouts encourage spontaneous connections among residents, promoting a sense of community and wellbeing. This trend is particularly evident in mixed-use developments where residential and commercial spaces coexist harmoniously, facilitating interaction and creating vibrant, inclusive environments.
The rise of hybrid work models, accelerated by global events, has heightened demand for wellnessfocused commercial real estate. Offices are evolving to incorporate biophilic design elements, which integrate natural elements into the built environment to enhance well-being. Green spaces, natural light,
ergonomic furniture, and spaces for physical activity are becoming standard features aimed at improving employee satisfaction, productivity, and overall health.
High-end residential properties are setting new standards by integrating wellness features that cater to health-conscious buyers. These residences offer state-of-the-art fitness facilities, spa-like bathrooms with therapeutic features, and architectural designs that promote a holistic living experience. From air purification systems to soundproofing technologies that reduce stress, every aspect is meticulously designed to enhance physical health and mental well-being.
There is a growing preference for residential communities that offer retreat-style wellness programs. These developments go beyond physical amenities to incorporate lifestyle-focused initiatives such as meditation sessions, nutritional workshops, and fitness classes as integral parts of daily life. Such initiatives appeal to a diverse demographic - from young professionals seeking a balanced lifestyle to seniors looking for active retirement communities that support their well-being.
Looking ahead, the future of real estate wellness promises continued innovation and integration of health-centric principles into property development.
As awareness of environmental sustainability and wellness-oriented lifestyles grows, developers and investors are likely to prioritize creating spaces that support physical, mental, and emotional well-being. Sustainable building practices, energy-efficient designs, and technologies that promote health will become standard considerations in real estate projects.
Furthermore, the demand for wellness-certified properties is expected to rise, driven by consumers who prioritize living and working in environments that contribute positively to their health. Certification programs, such as WELL Building Standard and Fitwel, are gaining prominence as benchmarks for evaluating the wellness attributes of buildings. These standards encourage developers to adopt evidencebased strategies that enhance air quality, water purity, lighting quality, and overall comfort levels for occupants.
In summary, real estate wellness represents a fundamental shift in how buildings are conceived, designed, and experienced. By prioritizing human health and well-being, stakeholders in the real estate industry are not only enhancing property values and occupant happiness but also contributing to broader societal goals of promoting healthier lifestyles and environments. The evolving landscape of real estate wellness underscores the importance of integrating advanced technologies, thoughtful design practices, and community-focused initiatives to create spaces that actively promote the well-being and nurtures physical, mental, and emotional wellness.


By Dr Nadine de Freitas - Les Nouvelles Esthetiques
Wellness tourism isn't merely a trend; it stands as the fastest-growing sector within the broader wellness industry. Drawing on insights from the Global Wellness Institute, we explore the latest trends propelling remarkable growth in this segment. From increased expenditures per visit to a surge in wellnessfocused trips, we dissect the factors reshaping the landscape of wellness and luxury travel.
In recent years, wellness tourism has emerged as a powerhouse in the travel and hospitality industry. Defined by experiences that prioritize health, relaxation, and personal well-being, this sector has witnessed exponential growth. According to the Global Wellness Institute, wellness tourism is experiencing robust expansion, outpacing overall tourism growth rates.
Several key factors contribute to the popularity of wellness travel:
•Health Consciousness: Increasing awareness of health issues and the importance of self-care has led travelers to seek destinations and experiences that promote well-being.
• Stress Relief: Modern lifestyles characterized by stress and burnout have prompted individuals to prioritize vacations that offer relaxation and rejuvenation.
•Personalization: Consumers are increasingly seeking personalized experiences tailored to their specific wellness goals and preferences.
1. Increased Spending Per Visit
There's a noticeable trend towards higher spending per visit among wellness travelers. This demographic is willing to invest in premium experiences that offer comprehensive wellness benefits, from luxury spa treatments to exclusive wellness retreats.
2. Surge in Wellness-Oriented Trips
The number of trips specifically focused on wellness has seen a significant increase. These trips range from weekend spa getaways to extended retreats that combine fitness, mindfulness, and cultural immersion.
Wellness travelers are exploring a wide range of destinations, from exotic retreats in Southeast Asia to wellness-focused resorts in Europe and Africa and wellness cruises in the Caribbean. This diversity reflects the growing global appeal of wellness tourism.
Looking ahead, several trends and innovations are set to shape the future of wellness travel:
•Integration of Technology: Expect advancements like AI-powered wellness apps and virtual reality meditation sessions to enhance the wellness travel experience significantly.
•Expansion of Wellness Offerings: Hotels and resorts will continue expanding their wellness offerings, integrating holistic wellness programs, healthy dining options, and mindfulness activities into guest experiences.
• Sustainability: There will be a heightened emphasis on sustainable wellness travel practices, including eco-friendly resorts, organic spa treatments, and experiences that promote environmental stewardship.
•Wellness for All: Accessibility and inclusivity will become increasingly important, with efforts to make wellness travel experiences available and enjoyable for travelers of all ages, abilities, and backgrounds.
The rise of wellness travel presents numerous opportunities for spa professionals:
Career Growth: There's increased demand for skilled professionals in wellness therapies, holistic treatments, and specialized wellness programs.
Entrepreneurship: Spa entrepreneurs can capitalize on opportunities to develop niche wellness offerings, collaborate with resorts, or create unique wellness retreats.
Training and Development: Continuous learning and specialization in wellness-focused therapies and practices will be crucial to meeting the evolving needs of wellness travelers.
Wellness travel represents a transformative movement within the tourism industry, driven by a growing consumer desire for health-centric experiences. As travelers prioritize health, relaxation, and personal well-being, the demand for wellness-oriented trips continues to soar. By embracing and understanding the trends shaping this sector, spa professionals can seize new opportunities and contribute to the evolution of wellness travel worldwide.

